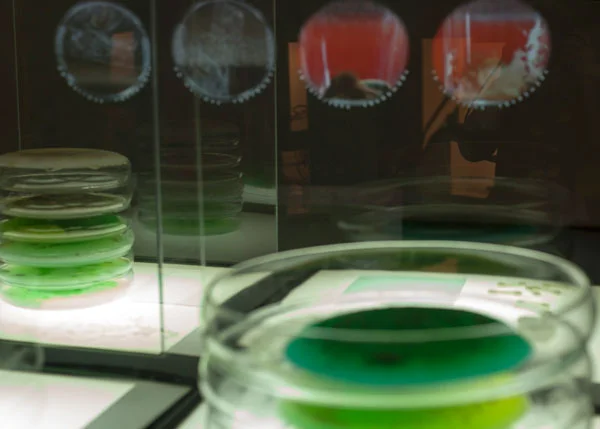

/
1
2
3
4
5
6
7
8
9
10
·
·
·
·
·
·
·
·
·
·